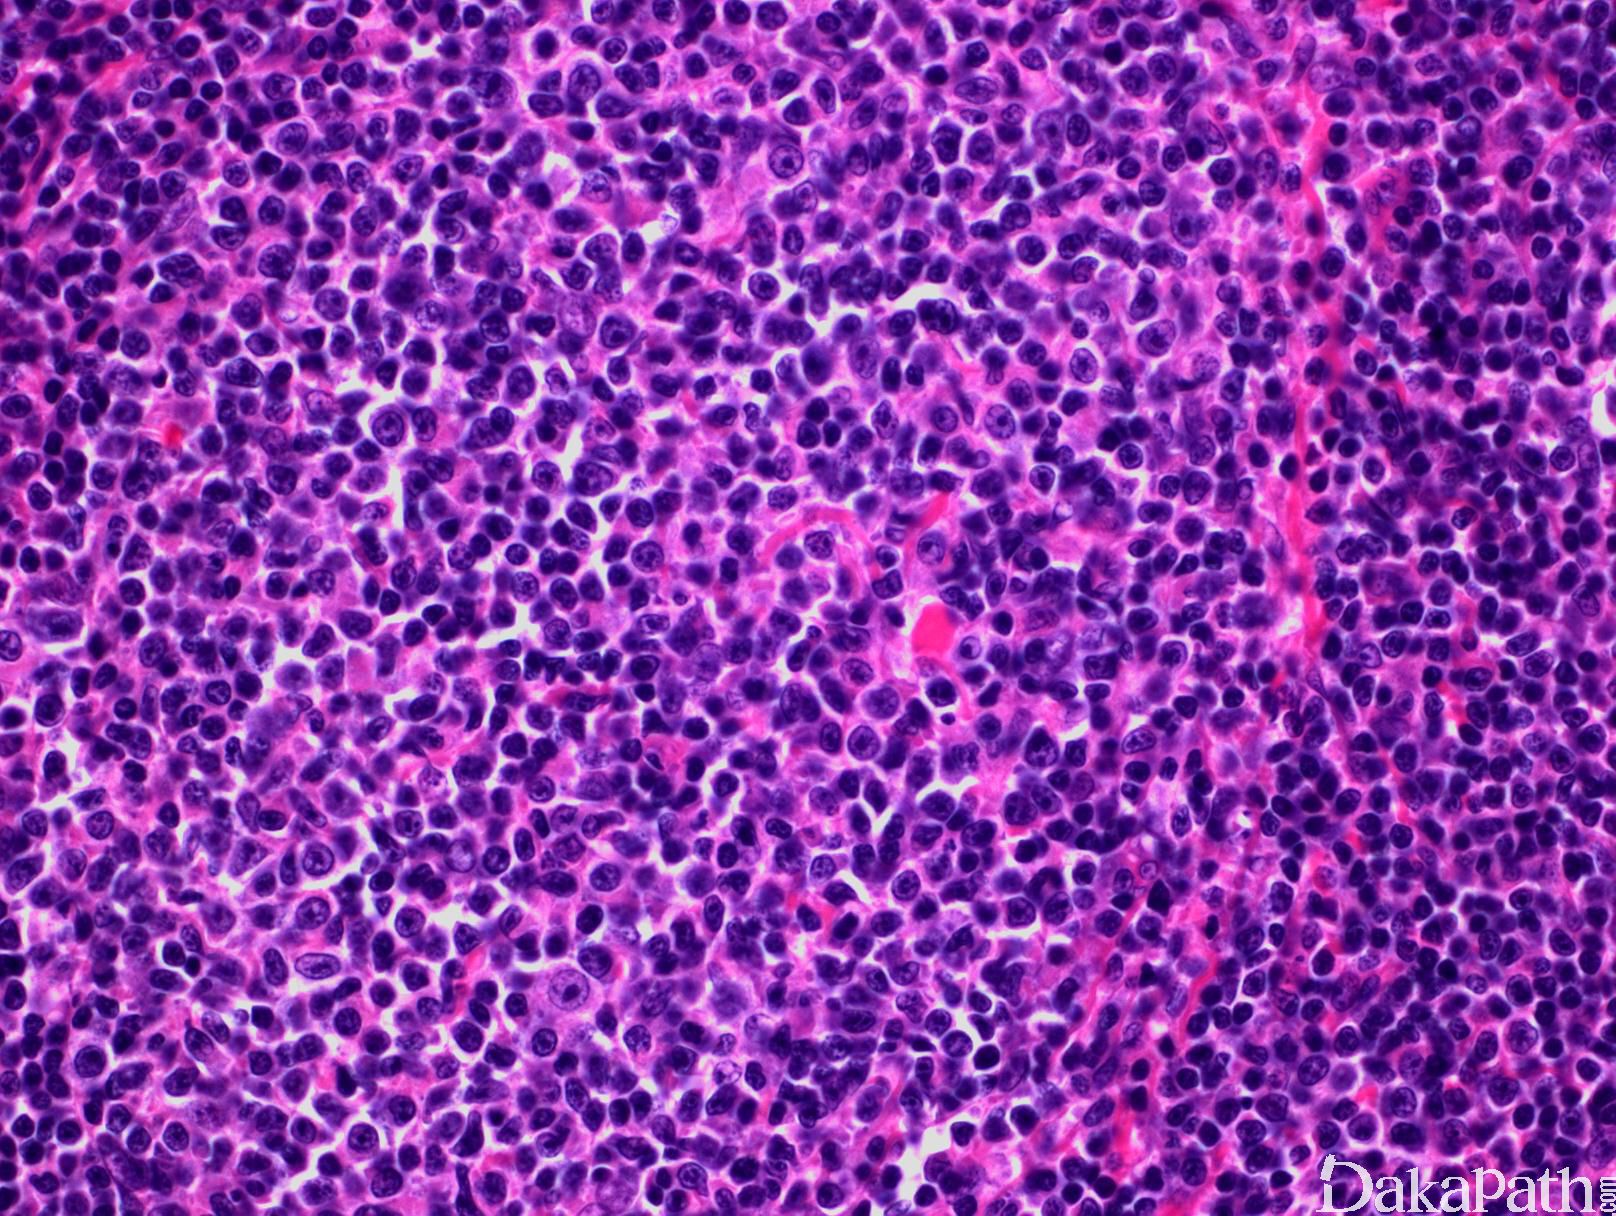

滤泡性淋巴瘤
Follicular Lymphoma, FL
概述:
系 B 细胞淋巴瘤,由生发中心 B 细胞组成,包括中心细胞和中心母细胞,呈现滤泡或至少部分滤泡生长模式,也有极少完全弥漫生长模式。
发病部位: 颈部和腹股沟淋巴结,并常累及脾脏、骨髓、外周血。罕见原发于结外器官组织,包括皮肤、胃肠道、睾丸等。
诊断要点:
发病中位年龄 60 岁,男女比例大致相等。常无症状,表现为全身淋巴结肿大和脾肿大。常累及骨髓和脾脏, 也会累及肝脏和外周血。其他结外组织(胃肠道,睾丸等)罕见累及。
淋巴结正常结构消失,代之以紧密排例、大小和形状一致的不正常滤泡,常累及整个淋巴结或浸润到胞膜外。套区变薄、不完整、消失或极性不在。有的同时存在弥漫浸润区。偶而滤胞呈现出形状不规则或匐行性生长(类似进行性滤胞中心转化, PTGC)。
滤泡由中心细胞和不等数量的中心母细胞组成,两种细胞随机散在分布,极性和“星空”细胞消失。滤泡之间或可见浸润中心细胞。中心细胞:较中心母细胞小,核形不规则成角或有核裂,胞质少。中心母细胞:核圆形或卵圆形,呈空泡状,可见 1 ~ 3 核仁,多靠近核膜。滤泡之间或可见肿瘤细胞侵润,系中心细胞,但胞核相对规则。
免疫表型:表达 B 细胞抗原如 CD20 和 CD19,CD10+,Bcl-6+,Bcl-2+,单克隆轻链。高级别 FL,CD10 阴性相对常见。滤胞间肿瘤细胞(低级别或高级别)常弱表达或不表达 CD10,边缘区分化区域(FL 伴边缘区分化)、骨髓或外周血中的肿瘤细胞也常不表达 CD10。滤胞间区的肿瘤细胞表达 Bcl-6 也减弱。
重链和轻链基因重排:单克隆重排有助诊断,但假阴性较高。
分级:根据高倍镜下母细胞 10 个视野平均计数(18mm 目镜,40x 物镜)。 1 级,0-5/HPF;2 级,6-15/HPF;3 级,>15/HPF (3A,混有中心细胞;3B,母细胞实性成片几乎无中心细胞)。1-2 级可合并称为低级。Ki67 值大多与级别相一致,少数低级别呈现较高 Ki67 值。
报告方式:滤泡>75%,“滤泡淋巴瘤”;滤泡 25-75%,“滤泡淋巴瘤,滤泡(百分比)和弥漫(百分比)”;滤泡<25%,“滤泡淋巴瘤,局灶滤泡”。
t(14;18),极少数 t(2;18)。检测方法包括染色体分析,FISH 和 PCR (前者更敏感)。低级别 FL 阳性率高(90%),高级别 FL 阳性率低。其他常见的染色体异常累及 1,2,4,7,8,X,17P 等。复杂的染色体核型预后较差。
除 Bcl-2 外,少数病例还有 Bcl-6 重组(有助不表达 Bcl-2 病例诊断)。
变异型:
- 弥漫性滤泡淋巴瘤 变异型 ( 弥漫为主型滤泡性淋巴瘤伴 1p36 缺失) (Diffuse Follicular Lymphoma Variant ): 大多数所谓弥漫性滤胞淋巴瘤,可能系有于所取标本不具代表性所致(如针穿刺活检),重复活检或活检不同部位淋巴结常发现滤胞成份。2017 年版 WHO 确认了存在新的弥漫滤泡淋巴瘤变异型,无 t(14;18),以弥漫生长成份为主,主要由中心细胞组成,但几乎所有病例能发现残存小滤泡(微型滤胞),弱或不表达 Bcl-2,CD10 阳性,几乎所有病例 CD23 阳性。常发生并局限于腹股沟淋巴结,病灶很少不扩散。大多数病例有 1p23 缺失,虽然不具特异性(普通 FL 也可以有此基因位点异常)。
- 睾丸滤胞性淋巴瘤 (Testicular Follicular Lymphoma): 多见于儿童,但成人也可发病。其生物学特性于普通结性滤胞淋巴瘤不同,没有 t(14;18),细胞形态为 3A,但预后良好,通常只需手术切除,不作进一步治疗。
- 滤泡内瘤变 /原位滤泡淋巴瘤(In Situ Follicular Neoplasia/In Situ Follicular Lymphoma): 淋巴结或淋巴组织结构形态 HE 染色无明显异常,但免疫组化检测出滤泡中心细胞和中心母细胞强表达 Bcl-2,只局限于滤泡或滤泡中的部分细胞,但可累及一个或多个滤泡,流式可检测到 CD10+单克隆 B 细胞,有 t(14;18)。滤泡内瘤变的临床意义不确定,病变本身进展成淋巴瘤的可能性较低,更大可能是先前或同时存淋巴瘤,需结合临床评估或进一步检查。如同时存在其它部位肿大淋巴结,应活检除外淋巴瘤特别是 B 细胞淋巴瘤。滤泡内瘤变需与滤泡性淋巴瘤累及部分淋巴结相鉴别,后者 HE 形态有异常,滤泡间也可能有肿瘤细胞。
- 十二指肠型滤泡淋巴瘤 (Duodenal-Type Follicular Lymphoma): 多见于中年人,发生于小肠,多数位于十二指肠第二段,其形态、免疫表型及细胞/分子遗传学与经典滤泡淋巴瘤一致,一般为低级别,累及黏膜和黏膜下层, 不累及肠系膜淋巴结。临床表现为局限性疾病,预后佳。有别于发生于胃肠道其他部位的滤泡性淋巴瘤及结性 FL 累及肠道,需要加以鉴别。
- 滤泡性淋巴瘤, CD10-, IRF4/MUM1+: 2017 年版 WHO 没有单列为 FL 变异型。见于老年人。形态学为高级别淋巴瘤(3A,3B),免疫组化 CD10-、MUM-1+、Bcl-6+,大多数病例 Bcl-2 阴性,少数阳性。无 BCL-2 基因易位,无 MUM1/IRF4 基因重组,但大多数病例有 BCL-6 基因扩增。预后不良。在诊断上,特别需要与大 B 细胞淋巴瘤伴 MUM1/IRF4 基因重组(Large B-Cell Lymphoma with IRF4 Rearrangement ) 相鉴别(见下)。

鉴别诊断:
反应性滤泡增生 :滤泡大小不一,中心细胞和中心母细胞极性分布,富含“星空”细胞,套区完整且不对称。不表达 Bcl-2,无 t(14;18)(q32;q21)。极少数滤泡性淋巴瘤和有的亚型不表达 Bcl-2,也无 BL-2 基因易位,要结合形态和其他免疫及分子生物学特征加以鉴别。
B 小淋巴细胞淋巴瘤 :弥漫生长伴散在增殖中心形成假性滤泡,但细胞构成不同,无套区,缺乏滤泡网状组织(CD21 阴性),不表达 CD10 和 Bcl-6。
淋巴结边缘区淋巴瘤 :呈弥漫性、边缘区或滤泡间生长,细胞大小不等或“单核样”形态,可发生滤泡“植入”性侵润,如同时伴有滤泡增生,则很难与滤泡淋巴瘤特别是有边缘区分化的滤泡淋巴瘤相区别。以滤泡间侵润为主,细胞多形性,伴浆细胞分化及残存的明显反应性滤泡有助边缘区淋巴瘤的诊断。免疫组化、细胞遗传及分子生物学测定也有助于鉴别。
结节性淋巴细胞为主型霍奇金淋巴瘤 :结节大,由小圆细胞组成,系套细胞,不表达 CD10 和 Bcl-6。中心细胞或中心母细胞很少。散在的肿瘤细胞(LP细胞)特征明显。
套细胞淋巴瘤 :可产生模糊结节生长方式,但常伴有弥散和套区侵润。细胞中小,形态单一,核不规则,无中心母细胞。表达 cyclin D1,一般不表达 CD10 和 Bcl-6。
大 B 细胞淋巴瘤伴 MUM1/IRF4 基因重组 (Large B-Cell Lymphoma with IRF4 Rearrangement ):主要发生于儿童和年轻成人,典型病例累及并常局限于颈部淋巴结和 Waldeyer 环。形态上可以是高级别滤泡性淋巴瘤 (3 级),或滤泡伴弥漫侵润,或弥漫增生如同弥漫大 B 淋巴细胞瘤。MUM1/IRF4 和 Bcl-6 强表达,至少半数病例表达 Bcl-2 和 CD10,少数也表达 CD5。大多数病例有 MUM1/IRF4 基因重组,常同时有 BCL-6 基因重组,但无 BCL-2 基因易位。少数病例无 MUM1/IRF4 基因重组,但有 MUM1/IRF4 强表达。侵袭性较儿童型滤泡淋巴瘤强,但经治疗后,预后良好。
预后:
临床表现为惰性,1-3A FL 的中位存活期超过 12 年。发病年龄大(>60 岁),晚期、多处淋巴结肿大、明显贫血、肿瘤级别高(3 级)、复杂的染色体核型
治疗:
对于无症状或早期患者,临床观察随访。有症状或晚期患者,常用化疗(CHOP)或放疗,骨髓移植。
